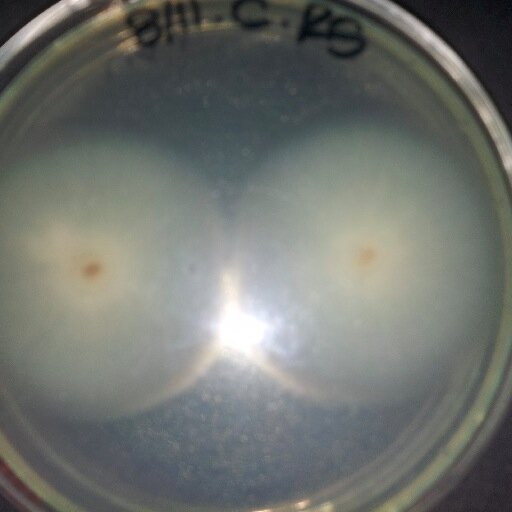

Daniel Lopez @lopezdanielr
Estudiante de Ing. Agroindustrial Guaro/Venezolano Deportista facebook.com/Daniel.mvp Venezuela Joined December 2009-
Tweets762
-
Followers269
-
Following797
-
Likes106
🚨 ¡ÚLTIMA HORA VENEZUELA! 🚨🇻🇪 Pánico y tensión durante la transmisión en vivo en el Programa del Dictador Nicolás Maduro. Las caras de Diosdado Cabello y Padrino López, se nota mucha tensión y muchísima ansiedad por la inseguridad. ¡EL CARTEL DE LOS SOLES TIENE MIEDO!
Ya no son tiempos en los que se insultaba al "Imperio", cuando se le retaba con la "furia bolivariana", ya no se oyen los epítetos altisonantes, pero además son poquitos los que se exhiben para la foto (que va al expediente por cierto), las caras son una mezcla de angustia y…
🚨 ¡ÚLTIMA HORA VENEZUELA! 🚨🇻🇪 Dictador Criminal Terrorista de Nicolás Maduro: "Vengan a por mi... Los espero aquí en Miraflores, no se tarden en llegar Cobardes" ¡SU DESEO SERÁ CUMPLIDO! 🔥
Todo el que se la da de "arrechito", a la hora del té, le tiembla el pulso para agarrar la taza.
Manuel Noriega se juramentó de manera ilegítima un 3 de octubre de 1989. Dos meses después era sacado a la fuerza por los Estados Unidos, y capturado por la DEA, todos sus colaboradores terminaron presos. ¡Cuando hay la voluntad política todo se puede!. #IntervencionMilitarYA
Maduro is an adversary and a dangerous madman who is openly threatening the United States and is willing to do anything to stay in power. He only cares about keeping himself and his thugs rich and must leave power to bring freedom to Venezuela. Congress must pass my STOP MADURO…
JP Guanipa a esta hora 🇻🇪😝
María Corina, no vamos a abandonarte. Venezuela será Libre!
Como presidente electo, exijo la liberación inmediata de María Corina Machado. A los cuerpos de seguridad que la secuestraron les digo: no jueguen con fuego.
Dios eres grande Que la honra y la gloria sea para nuestro Padre Dios. Venezuela libre
VENEZUELA LIBRE!!!!!!!
Hoy cerramos un año histórico! El 2024 logramos la unión de todo un país y la inmensa victoria de la voluntad de un pueblo decidido a vivir con dignidad y Libertad. Ahora a prepararnos: todos somos responsables de cobrar nuestro triunfo. En enero nos vemos en las calles de…
Corre fuerte rumores sobre Elvis Amoroso Presidente del CNE Venezuela 🇻🇪. Al parecer según rumores indican que el mismo está en Argentina 🇦🇷 fuertemente custodiado por las autoridades de dicho país después de algunas negociaciones. Lo que sí es cierto es que dicho personaje sabe…

𝑭𝒆𝒚𝒄𝒉�... @Feycherry2
769 Followers 1K Following 𝑳𝒊𝒃𝒓𝒂𝒏𝒂♎ 𝑳𝒊𝒄𝒅𝒂. 𝑹𝑹𝑯𝑯, 𝑨𝒆𝒓𝒐𝒎𝒐𝒛𝒂, 𝑫𝒆𝒄𝒐𝒓𝒂𝒅𝒐𝒓𝒂, 𝑱𝒖𝒔𝒕𝒂⚖ 𝑨𝒎𝒊𝒈𝒂🤩 𝑨𝒎𝒐 𝒎𝒊 𝒑𝒂𝒊𝒔🌹𝑽𝒆𝒏𝒆𝒛𝒖𝒆𝒍𝒂 libre🇻🇪
Janeth G @jnbenitez
25K Followers 11K Following
Andrea ⭐️⭐️�... @AndreaCMB23
264 Followers 946 Following Mis pasiones son las películas 🍿, series de TV 📺 y por supuesto Taylor Swift
Cruz Unda @Cruz50503257
5 Followers 46 Following
miguel alejandro h. @migueelAlejandr
100 Followers 168 Following
Zayda Escalona @96Zaydaceu
6 Followers 29 Following
Jose Gonzalez @JoseGon56646387
76 Followers 225 Following
Daniela @dany_herrera21
3K Followers 4K Following
Enrique @kike030693
13 Followers 97 Following
LoboSiveriano @Frank10613865
4 Followers 57 Following
SMALL PC JDLV @smallpcjdlv
80 Followers 429 Following Tienda Online, venta de electronica, computacion y papeleria. Correo: [email protected]
yelisyaquelin @yelisnieves
18 Followers 69 Following
Fiore☆ @Fioree95
374 Followers 597 Following Que atrevidos los que dicen que No puedo ser FELIZ ✌ 1/9 😍💕 Estudiante de Lic. en Psicopedagogia en UAA 📚📒👓📏✏✂
Jesus David Ferreira @jesusdavid2206
45 Followers 79 Following
Daniela Duque Perez @DanielaDuquep
14 Followers 118 Following
☺Geneziiz ♥♕ @genesisnelo3
45 Followers 131 Following #Estudiante de Administración Financiera #CUFT, Feliz de la Vida A Lado de Mis Seres Queridos
lavevamariapb @MariapBracho
81 Followers 185 Following
Marly Castro @castromarly64
17 Followers 115 Following
yonetzi escobar @yonetzi_escobar
40 Followers 347 Following
Entidad Creativa @CreativaEntidad
1K Followers 3K Following Publicidad, Diseño, Paginas Web, PoP, Venezolano
Carolina @870f72f678454a6
6 Followers 81 Following
beljaii montoya @beljaii9
7 Followers 39 Following
Yerly Colmenares @YerlyColmenares
277 Followers 1K Following
Edangel Herrera @EdangelHerrera
151 Followers 528 Following
stephany alvarez @Stefanypaoli
256 Followers 73 Following NadieTieneQueSaber https://t.co/KTbbJIiwnw
jimena @jimena_zj
545 Followers 104 Following
Los Bachilleres @losbachilleres
15K Followers 15K Following Columna de eluniversitario en Twitter @eluniweb en la que podrás conseguir toda la información sobre el ingreso a las universidades venezolanas.
MariaG Zapata @mariagzapata8
8 Followers 21 Following Valencia. Cuasi Ing. en Telecomunicaciones, I'm naturally blonde, so please talk slowly
Liz hernandez @lizmahrndz
29 Followers 73 Following Soy fanática del hacer mas que del decir.. Futura ingeniero agroindustrial.. :-*
loreannys hernandez @Lh19Hernandez
22 Followers 146 Following chika liinda con ganas de seguir adelante♥(⊙o⊙)
Wendy Ramirez @WendySRamirezO
167 Followers 386 Following Licenciada en Diseño Gráfico. Todo los días Dios nos da un momento en que es posible cambiar todo lo q nos hace infelices...
Darwin PJ @DarwinM18
696 Followers 2K Following Creyente En Dios Por Encima De Todo! Orgulloso De Ser Venezolano Comprometido En La Lucha Por Tener Un Mejor Pais! JUSTICIERO100% https://t.co/6xYlMEuLAF
Albha Mariina @AlbhaMariina
55 Followers 493 Following Futura Ingeniera promo 2014. El Tiempo de Dios es perfecto.!
Johaniitaa Hernández @Johaniitaa18
64 Followers 465 Following ♥Gracias a *Dios* y a mi *Familia* por todo lo que me han dado♥ **LOS AMOOO** *Sigueme y te Sigo* =)
MaryBoquitas👩 @Maryboquitas12
2K Followers 2K Following ITG: @MARYBOQUITAS Comunicadora Social💛 Escritora de @KENArevista♀ Adicta a la DEMOCRACIA🏳 ItaloVenezolana💯
Dulce Fitness @dulcefitness
617 Followers 1K Following Aqui encontraras disponibilidad de productos para tener una alimentacion mucho +saludable. sinazucar singluten [email protected] Instagram: @dulcefitness
Annyi Salon♥ @242Paola
44 Followers 63 Following Loca,Divertida,Chevere! Asi me considero! Sigueme y conoceme :*
Richard Rodriguez C. @RichardProgreso
845 Followers 2K Following Medico General en Formación / Paramedico/ Activista de @VoluntadPopular !
Denzel C @1Josbel
11 Followers 43 Following Vivir cada día, como su fuera el último día de mi vida...😜
dayana gimenez @gimenezzdayana
25 Followers 318 Following
William Bruce Bailey @yinnadayana
147 Followers 423 Following Nunca me ha importado nada de esta vida y lo que me importo tiene fechas que no recuerdo y cicatrices en mi piel que no se borraran jamas
Iván Simonovis @Simonovis
908K Followers 5K Following Investigador Criminal. Ex Preso politico venezolano 2004-2019. Investigador Criminal / Analista de Inteligencia #Venezuela
Ya Casi Venezuela @yacasivenezuela
278K Followers 82 Following El movimiento que cambiará el rumbo de nuestro país. #YaCasiVenezuela
Climaco48* @JorgeNa62226511
120 Followers 698 Following viviendo un día a la vez, agradecido con Dios¡¡¡¡
💕☀️M o l l y�... @Moollyybb
14K Followers 42 Following New Account🩷✨ Suscríbete a mi telegram gratis en el enlace de mi Bio💙
Grazi Mourao @eugrazimourao
240K Followers 231 Following Miami 📍🇧🇷🇺🇸⠀⠀⠀⠀⠀⠀⠀ ⠀⠀⠀⠀⠀⠀⠀ ⠀⠀⠀⠀⠀⠀⠀⠀⠀ ⠀ ⠀ Insta: grazimourao 🔥 ❤️🔥 ⠀⠀⠀⠀ ㅤ ㅤ ㅤ ㅤ ㅤ ㅤ ㅤ ㅤ ㅤ ㅤ ㅤ ㅤ ㅤ ㅤ ㅤ ㅤ ㅤ ㅤ ㅤ ㅤㅤ ㅤ ㅤㅤㅤ ㅤ ㅤ ㅤ ㅤ ㅤ ㅤ ㅤ ㅤㅤ ㅤ ㅤ ㅤ Links ⬇️
ErikDPrince @realErikDPrince
564K Followers 2K Following Podcast: Off Leash with Erik Prince Author: Civilian Warriors
INAMEH @INAMEH
805K Followers 389 Following Instituto Nacional de Meteorología e Hidrología. Hidrometeorología al servicio de nuestra Patria y la Gestión de Riesgos ☎️ +58 (212) 535 3071 / 535 3072
𝐃𝐀𝐍 🕷️ @1spiderdan
247K Followers 307 Following NO SOY UNA PVTA IA / Historias feas pa' gente bonita 🌷. Todas mis Redes: https://t.co/Wc9C4QWrev NUEVO VIDEO EN YOUTUBE https://t.co/dSBsAcLejb
Vladimir Villegas @Vladi_VillegasP
157K Followers 1K Following Periodista venezolano. Articulista y defensor de la constitución de 1999. Conductor del programa @vladialacarta➡️ https://t.co/QG4IXISn3U
María Corina Machado @MariaCorinaYA
6.3M Followers 5K Following Venezolana, mamá de 3, ingeniero y liberal. Sólo concibo mi vida en Venezuela y en democracia. La libertad se conquista cada día. #GanóVzla
Edmundo González @EdmundoGU
1.2M Followers 235 Following Presidente Electo de Venezuela. Esposo, padre y abuelo. Diplomático. Servidor público. 🇻🇪. ¡#VzlaGanó!
Corina Yoris @yorisvillasana
98K Followers 1K Following Filósofa, profesora universitaria y luchadora por un país democrático. Miembro Principal de la Comisión Nacional de Primaria 2023.
Lo Sinson @notafaso
567K Followers 43 Following
@InforTvenezuela @InforTvenezuela
85K Followers 13K Following Medio lider en Venezuela, ofreciendo información de última hora ' ¡Mantente informado! 📰 Telegram: https://t.co/sawYArzSh1
Las Verdades de Eleaz... @verdaddeeleazar
191K Followers 640 Following
Papuchini @danoxo794
1K Followers 103 Following
Carolina Duarte @CaroDuarteArte
90K Followers 66 Following Escritora📝- Actriz🎭 - Politóloga - Vallenata.
Portalcalidad @portalcalidad
464 Followers 31 Following Portal WEB de sistemas de gestión. Información, asesoramiento, y debate en torno a ISO 9001, ISO 14001, y mucho más.
Aminta R. Pérez C. @AmintaPerez3535
42K Followers 254 Following Soy la Madre de ÓSCAR A. PÉREZ, Héroe de América! gran ser humano, un luchador por la libertad de Venezuela, y defensor de los DDHH.
puppy girl {+18} @Puppygirl4628
8K Followers 94 Following
Datanalisis @datanalisis
330K Followers 2K Following Firma de inteligencia de mercados 📊 Información oportuna para la acción💡 Toma decisiones acertadas💰 Contáctanos: @datanalisis
Liceidy ♡ @Liceidy_96
1K Followers 48 Following
Giuliana @GiulianaBarzan
198 Followers 152 Following
Migración Colombia @MigracionCol
123K Followers 417 Following Cuenta oficial de Migración Colombia. Directora: Gloria Esperanza Arriero López @Gloarriero .
Reporte Ya @ReporteYa
1.2M Followers 86K Following Red pionera de Periodismo Ciudadano y alfabetización digital. Ofrecemos capacitación en el uso efectivo de RRSS y brindamos información en tiempo real
Estudiantes de Mérid... @EstudiantesMEFC
54K Followers 23 Following ⚽ Cuenta oficial de Estudiantes de Mérida F.C Bicampeón Nacional. 🏆🏆 #ElEquipoDelPuebloMerideño 🔴⚪
1Weather @OneLouderApps
4.7M Followers 38K Following 1weather - trusted source of weather for 35M users
Daniela @dany_herrera21
3K Followers 4K Following
NTN24 Venezuela @NTN24ve
4.7M Followers 4K Following Cuenta oficial del canal @NTN24 dedicada a Venezuela.
CNN en Español @CNNEE
22.4M Followers 226 Following CNN en Español es tu principal fuente de información y breaking news. Síguenos también en WhatsApp: https://t.co/yKiftQVXmp
NTN24 @NTN24
4.8M Followers 297 Following Somos el canal de las Américas ¡Solicítelo a su cable operador!
GYM 🏋️♂️ @Ejercitandome
203K Followers 51 Following Los mejores consejos para tu salud y entretenimiento!
Noticias Barquisimeto @NoticiasBqto
49K Followers 867 Following 🗞️ Premio Nacional de Periodismo Digital 🇻🇪 Noticias de #Barquisimeto #Lara #Venezuela y El Mundo 📌 #Sucesos #Política #Deporte Comunidades y mucho más.
Micro General @microgral20141
86 Followers 1 Following Microbiología General. IV Semestre. Ingeniería Agroindustrial. UCLA.
yelisyaquelin @yelisnieves
18 Followers 69 Following
Fiore☆ @Fioree95
374 Followers 597 Following Que atrevidos los que dicen que No puedo ser FELIZ ✌ 1/9 😍💕 Estudiante de Lic. en Psicopedagogia en UAA 📚📒👓📏✏✂
Anuncios de Venezuela... @AnuVez
45K Followers 2K Following Publicidad en redes sociales, ventas por internet. Si deseas crecer con tu producto, marca o servicio, ponemos nuestra plataforma a tu disposición. No Bots
Jesus David Ferreira @jesusdavid2206
45 Followers 79 Following